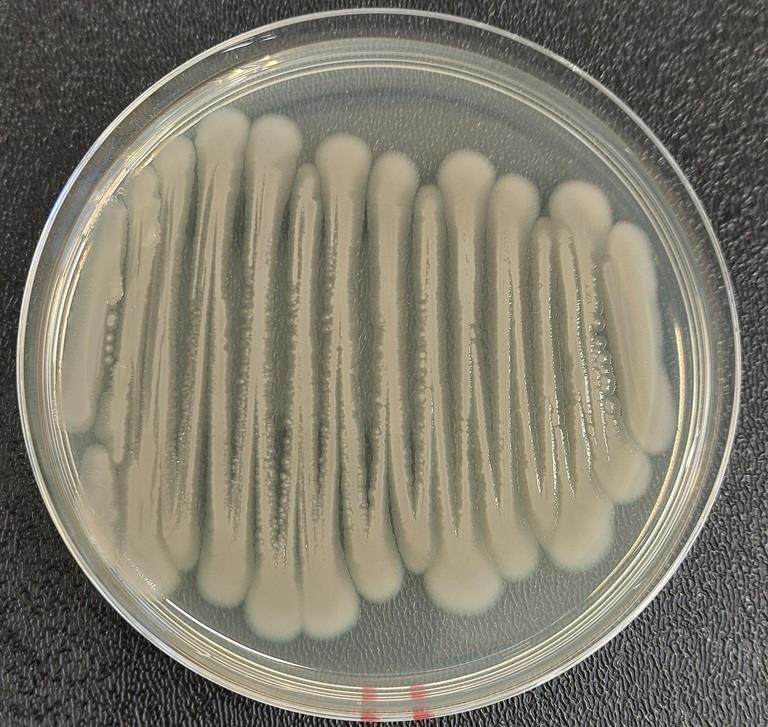

News and Opinion
Keeping you up to date with what's happening at Incotec around the world. Here you can find the latest news about our business, events, new product launches and seed industry insights.

Bruno Hoeltgebaum shares views in Seed World
8 October 2024: Bruno Hoeltgebaum, Business Director at Incotec, is one of the experts discussing regenerative agriculture in an article in Seed World Europe.

New film coat for sunflower launched at Euroseeds
03 October 2024: Introducing the newest microplastic-free top performer. Disco Blue L-1523 was developed to meet customer requirements for an intense blue film coat.

OPINION: Does film coating affect seed performance?
01 October 2024: In the first of a series of articles, Carolina Pereira Cardoso discusses the benefits and challenges of seed film coating, and how it contributes to seed vigor and crop yield.

Incotec lecture at Seed meets Technology
10 September 2024: At Seed meets Technology on 24 September, Incotec’s Brechje Veerman and Chloé Martin will deliver a lecture on what regenerative agriculture is, and what it means from a seed...

OPINION: Rhizobia in sustainable ag: specificity is key
12 September 2024: Unlock the potential of rhizobia in sustainable agriculture. Learn how these bacteria aid nitrogen fixation and promote sustainable agriculture for the future.

OPINION: The role of Pseudomonas: friend or foe in agriculture
19 September 2024: Carola Peters explores the significant role of Pseudomonas in plant growth promotion, disease control, and sustainable agriculture practices.
OPINION: The Bacillus family has it all: biostimulant, biofungicide, bioinsecticide
29 August 2024: Due to their many beneficial effects, there are several uses of Bacillus spp. in agriculture. But who does what, and how does it work?

OPINION: The challenges of applying microbes to seed
06 August 2024: The challenges that come with each seed coating method when it comes to direct application of compounds such as microbes, nutrients and plant protection products.

OPINION: Mitigating abiotic stress in crops
19 June 2024: Abiotic stress from factors like drought, salinity and temperature, poses significant challenges. Our paper looks at strategies to enhance crop resilience and mitigate these challenges.

Incotec and Croda release whitepaper on abiotic stress
27 may 2024: The report 'Mitigating abiotic stress to create resilient crops' has been produced with input from the top experts in the field from Incotec and Croda as well as from other sources

Fad or Future?
14 May 2024: In the first of a two-part article in Seed World Europe, industry experts, including Bruno Hoeltgebaum, Business Director at Incotec, share their views and tell us what companies like...

Incotec promotes partnerships for sustainability at ISF’s Holland Pavilion
07 May 2024: Incotec is open for smart partnerships with other companies and institutions, especially if this means accelerating in the fields of sustainability and innovation.

Incotec's Rob Pronk among experts views in Seed World article
08 May 2024: In a recent article in Seed World, Rob Pronk is one of the experts sharing views on the move toward more sustainable agriculture, the importance of seed treatment in achieving that, and...

Highlighting global presence and local solutions at ISF 2024
07 May 2024: This year the World Seed Congress celebrates 100 years of the International Seed Federation (ISF). At this special edition of the annual congress, Incotec shows that it is a truly global...

Han Botterhuis Incotec on Seed Valley Board
09 April 2024: Han Botterhuis, site director Incotec Europe, has joined the Seed Valley Board.

Reducing Effluent Water Disposal
Reducing effluent water disposal at our facility in South Africa is an example of Incotec's commitment to becoming more sustainable

Seed Technology central theme at Thai workshop
5 March 2024: Incotec’s Ernest Fong, Business Development Manager, and Tomoko Sakata, Research and Technology Manager Asia Pacific, will address a number of advanced seed technology topics as key...

UPDATE: Sustainable innovation from seed to harvest
28 February 2024: We have updated our booklet ‘Sustainable innovation from seed to harvest’. Download here and learn how we leverage smart science to maximize land productivity and support the UN's...

Incotec donates to Food Bank West-Friesland
14 February 2024: In an internal competition (the "Purpose In Action Award") Incotec won an award in the Health, Safety and Welfare category for working with ambassadors who are committed to further...

Seed Technology Seminar Thailand
23 January 2024: What can seed technology do for crops in Thailand? In a seminar on Feb 1st Incotec’s Tomoko Sakata and Ernest Fong will update you on the benefits and newest developments
Would you like more information on any of these articles?

Microplastic-free seed coatings
Helping customers get ahead of the ban on miicroplastics in seed coatings, we are expanding our line of microplastic-free products for vegetables and field crops.
Read more